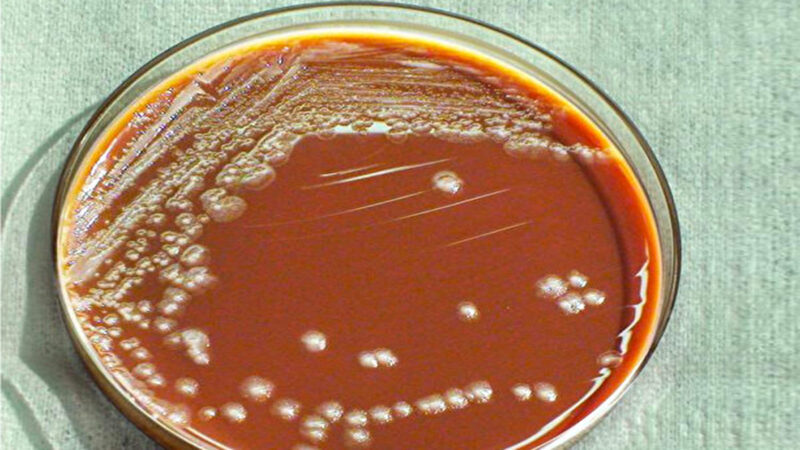

【新!唐!人:北京時間2019年11月15日訊】週二(12日),中國有2人在北京確診鼠疫。消息公布後,引發民眾對這種遙遠、恐怖的高度傳染疾病可能蔓延的恐慌。
北京市朝陽區政府稱,兩名感染者來自內蒙古,經過專家會診,確認診斷出肺鼠疫。
日前,北京朝陽醫院醫生李積鳳在社交媒體上寫道,兩名患者在11月3日到北京朝陽醫院就診,她接診了其中一名中年男子,該男子當時正在發燒,並表示自己已連續十天呼吸困難。男子此前在內蒙古一家醫院求治,但病情沒有好轉,他的妻子也出現了發燒和呼吸問題。
「經過這麼多年的專科培訓,對於絕大多數呼吸系統疾病的診療,我已駕輕就熟,」李積鳳寫道。「但是這一次,我看了又看,完全推測不出是什麼病原體導致的肺炎,只覺得是少見病。」該貼文由中國醫療新聞網站「健康界」發布,隨後被刪除。另據《紐約時報》指出,中共審查機構指示國內網站「屏蔽和控制」與鼠疫相關新聞的在線討論。
鼠疫有發病急、病程短、死亡率高、傳染性強、傳播迅速的特徵,曾在中世紀引發大規模死亡。這個被稱為「黑死病」疾病有多嚴重,又如何傳播?民眾怎樣才能避免成為感染者?
鼠疫——中世紀的「黑死病」
鼠疫是高度傳染的致命疾病,曾經在14世紀的歐洲大爆發,導致1/3人口喪命,總數超過五千萬人,並蔓延至亞洲、南美洲和非洲。因為死者的皮膚會出現黑斑,所以被稱為「黑死病」。

近年來,在世界一些地區亦出現小型鼠疫爆發。2017年,馬達加斯加出現半個世紀以來最嚴重的鼠疫疫情。
鼠疫是由鼠疫桿菌(yersinia pestis)引起,老鼠等齧齒動物能夠攜帶病菌,並通過跳蚤傳播。當人類被攜帶病菌的跳蚤叮咬後,就會感染鼠疫。最常見的鼠疫是腺鼠疫。
如果感染發生在肺部,則稱為「肺鼠疫」。肺鼠疫傳染最為迅猛,因為這種類型的鼠疫可以通過飛沫傳染,根據美國國家衛生研究院(NIH),當一個患有肺鼠疫的病人咳嗽時,帶有病菌的飛沫就會進入空氣,吸入者就可能感染,「流行可能始於此」。
處理感染者或感染動物的屍體,若接觸了帶有病菌的組織和體液,也可能感染。
鼠疫常見的三種形式包括:
● 腺鼠疫:淋巴結感染
● 肺鼠疫:肺部感染
● 敗血性鼠疫:血液感染
鼠疫的潛伏期通常為2~8天,但是肺鼠疫從感染到發病的時間可短至1天。
鼠疫的發病症狀
鼠疫的典型症狀為:
● 突然發燒、打冷顫
● 頭痛
● 身體疼痛、虛弱
● 噁心嘔吐
感染腺鼠疫者會出現淋巴結腫脹、疼痛,位置通常在腹股溝處。肺鼠疫會表現出嚴重咳嗽、呼吸短促、深呼吸時胸部疼痛等呼吸道症狀,通常伴有血痰。敗血性鼠疫則可能出現腹痛、腹瀉、出血等症狀。
如果發生類似症狀,應立即就醫。特別是曾在鼠疫流行地區旅遊的人,應將該情況告知醫務人員。
鼠疫如何治療?
鼠疫的治療方法主要為使用抗生素。在出現症狀之後,若立刻治療,則治癒率高。若在症狀出現後24小時內未治療,死亡風險會增加。
世界衛生組織指出,腺鼠疫的死亡率為30%~60%。肺鼠疫若未能及時診斷和治療會致命,而敗血性鼠疫在嚴重症狀發生前就可能致命。

鼠疫的傳播途徑、症狀和嚴重程度。點擊看大圖。(大紀元製表)
如何預防鼠疫感染?
目前,醫學界尚無有效疫苗可以預防鼠疫。但民眾可以通過如下方法進行預防:
1. 清除鼠窩
清除房子、車庫等環境周圍可能隱藏的老鼠窩,包括清除廢棄雜物、石頭堆、垃圾堆等。
2. 使用含DEET的驅蟲劑
在去戶外、野外或老鼠較多的地方時,可以用含DEET的驅蟲劑來防跳蚤叮咬。
3. 避免家裡寵物沾染跳蚤
貓、狗等動物也可能通過跳蚤把病毒傳染給人。因此如果家中養有寵物,可在詢問獸醫之後,使用特定的產品為寵物防治跳蚤,並儘量不要與寵物同睡。
4. 避免接觸可能感染的動物
如果發現可能因感染而生病或死亡的動物,不可用手觸摸,或須戴手套處理,避免與病菌接觸。
5. 根據需要戴口罩
生活在疫情地區的民眾,可以根據需要通過戴口罩來自我保護。但世界衛生組織指出,口罩必須妥善使用和處理,如果方法不當,可能依舊感染或成為感染源。
資料來源:WHO、CDC、NIH MedlinePlus、Mayo Clinic
──轉自《大紀元》
責任編輯:文匯